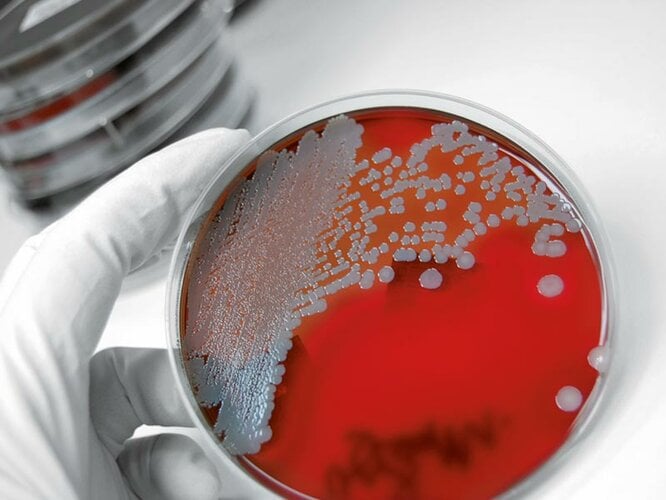

à ajustement mécanique
Série B
Processus d’incubation fiables et reproductibles
Une étuve bactériologique de BINDER est la solution idéale pour des processus d’incubation stables.
Les étuves bactériologiques à convection naturelle ou forcée répondent parfaitement aux exigences en termes de croissance ou d’incubation des cultures microbiologiques.
Elles garantissent des résultats reproductibles dans tous les tests de routine en laboratoire, même pour des débits de lots élevés en fonctionnement de longue durée.
La nouvelle génération d’étuves bactériologiques se démarque à la fois par la meilleure efficacité énergétique sur le marché et par la haute précision de température, grâce à la technologie APT.line™.
Choisissez le produit adapté à vos besoins spécifiques.
Nos vice-présidents Peter Wimmer et Michael Binder-Pfaff expliquent les nombreux avantages de nos étuves bactériologiques standard.
Découvrez ici tout ce qu’il y a à savoir sur les étuves bactériologiques
Les étuves microbiologiques fonctionnent de manière extrêmement fiable, constante, sûre et offrent les meilleures conditions de culture pour des processus d’incubation stables, et ce avec un volume intérieur généreux. Elles garantissent des résultats optimaux, reproductibles pour tous les tests de routine en laboratoire.
Chaque étuve bactériologique séduit par l’utilisation d’une technologie de pointe associée à une qualité maximale de matériaux et de fabrication, et assure une température constante.
La chambre de préchauffage à technologie APT.line™ permet d’atteindre une grande homogénéité thermique, la température peut être réglée au dixième de degré.
Avec la routine de désinfection à 100 °C, chaque étuve bactériologique BINDER présente un risque réduit de contamination et permet un nettoyage facile, avec peu d’efforts, grâce à l’intérieur en acier inoxydable et sans éléments encastrés. De cette manière, les bactéries ne peuvent pas incuber et les échantillons sensibles peuvent être conservés dans des boîtes de Pétri et utilisés ultérieurement.
BINDER est synonyme d’étuves bactériologiques d’origine ! Découvrez également les détails techniques de nos étuves à CO₂. Cela en vaut la peine !
BINDER propose des étuves bactériologiques entièrement automatisées de différentes séries et de différents types, conçues pour répondre à différentes exigences et disposant également de compétences numériques.
La série B est composée d’étuves microbiologiques à ajustement mécanique, la série BD fonctionne par convection naturelle à l’intérieur. Avec la série BF, BINDER a conçu des étuves bactériologiques qui garantissent un équilibre thermique rapide après l’ouverture de la porte, pièce par pièce, grâce à la convection forcée.
Pour des contrôles d’hygiène ou en microbiologie, BINDER a l’étuve bactériologique adaptée à chaque application. En tant que fournisseur complet dans le secteur des étuves microbiologiques, BINDER se distingue par la qualité et la précision de ses produits, pour les meilleures conditions d’incubation et des résultats reproductibles à tout moment.
Elles sont extrêmement faciles à utiliser et à régler. Pour toutes les tâches d’incubation et les applications dans la recherche, la médecine, la biologie, la biotechnologie, la production et l’assurance qualité, les étuves bactériologiques et les couveuses de BINDER constituent le bon choix. Vos cellules et vos échantillons vous en seront reconnaissants, et ce à un prix toujours aussi intéressant et avec des accessoires optimaux.
Depuis des décennies déjà, les produits BINDER jouissent d’une bonne réputation dans la recherche et l’industrie. BINDER est votre spécialiste des étuves bactériologiques et des appareils à CO₂ pour les secteurs de la recherche et de l’industrie. Vous trouverez plus d’informations sur les appareils de laboratoire BINDER, sur les étuves bactériologiques à convection naturelle et également sur nos étuves à CO₂ ici sur notre site Internet.